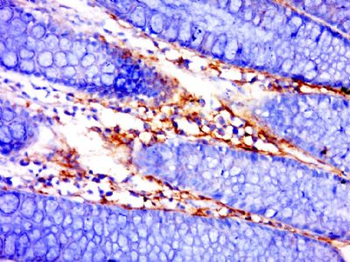
IFNK Polyclonal Antibody

You have no items in your shopping cart.
You have no items in your shopping cart.
| Catalog Number | orb1419604 |
|---|---|
| Category | Antibodies |
| Description | Rabbit polyclonal antibody to IFNK. |
| Clonality | Polyclonal |
| Species/Host | Rabbit |
| Conjugation | Unconjugated |
| UniProt ID | Q9P0W0 |
| Tested applications | ELISA, ICC, IF, IHC-Fr, IHC-P |
| Storage | Maintain refrigerated at 2-8°C for up to 2 weeks. For long term storage store at -20°C in small aliquots to prevent freeze-thaw cycles |
| Alternative names | Interferon kappa, IFN-kappa, IFNK |
| Research Area | Epigenetics |
| Note | For research use only |
| Expiration Date | 12 months from date of receipt. |
Tissue/cell: human colon carcinoma; 4% Paraformaldehyde-fixed and paraffin-embedded; Antigen retrieval: citrate buffer (0.01M, pH6.0), Boiling bathing for 15 min; Block endogenous peroxidase by 3% Hydrogen peroxide for 30 min; Blocking buffer (normal goat serum) at 37°C for 20 min; Incubation: Anti-IFNK Polyclonal Antibody, Unconjugated 1:400, overnight at 4°C, followed by conjugation to the secondary antibody and DAB staining.
WB | |
Bovine, Canine, Equine, Goat, Guinea pig, Porcine, Rat, Sheep | |
Human | |
Rabbit | |
Polyclonal | |
Unconjugated |
IF, IHC-Fr, IHC-P | |
Human | |
Rabbit | |
Polyclonal | |
Unconjugated |
Participating in our Biorbyt product reviews program enables you to support fellow scientists by sharing your firsthand experience with our products.
Login to Submit a Review